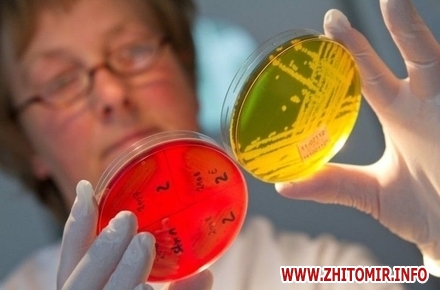

У Житомирській області щорічно на збудники паразитарних хвороб обстежується до 500 тис. осіб. У 2017 р. було обстежено 433573 осіб, що становить 35% від числа проживаючих в області.
Про це інформує прес-служба ДУ «Житомирський обласний лабораторний центр Міністерства охорони здоров’я».
«Серед обстежених виявлено інвазованих 9827 осіб, загальна захворюваність становить 791,7 на 100 тис. населення і в порівнянні з минулим роком захворюваність зменшилась. За останні роки захворюваність паразитозами зменшується, але це відбувається скоріше за рахунок низької виявляємості та зниженому охопленню обстеженнями. В структурі захворюваності на першому місці залишається ентеробіоз (36,3%), потім геогельмінтози (33,6 %) та кишкові найпростіші (29,9%). Реєструвались поодинокі випадки дирофіляріозу (3 випадки у Житомирському, Коростенському районах та м. Житомир)», - йдеться у повідомленні.
«З числа інвазованих 67,3 % – це діти до 17 років, в т.ч. 42,0% – діти організованих колективів. Всього було виявлено інвазованих дітей 7686, з них гостриками – 3241, кишковими найпростішими – 1938. В структурі захворюваності дітей в організованих колективах переважають паразитози, які передаються контактним шляхом, так ентеробіоз становить – 60,0%. Інвазовані паразитозами діти проліковані, в основному, за рахунок батьків, масова дегельмінтизація проведена в дитячих закладах, де ураженість ентеробіозом становила 15% і вище. Всього охоплено масовою дегельмінтизацією 209 дітей (Овруцький, Олевський, Житомирський райони). Діти організованих колективів обстежуються на ентеробіоз, геогельмінтози та кишкові найпростіші за планом. Середньообласні показники охоплення обстеженнями на гельмінтози дітей ДНЗ, учнів 1-4 класів загальноосвітніх шкіл становлять – 30-70%; на кишкові найпростіші – 10-30%», - інформують в лабораторному центрі.
Як повідомляв Житомир.info, з 12 по 14 вересня 2017 року 6 працівників, які харчувалися в їдальні комбінату в с. Гулянка Коростенського району, госпіталізували з кишковою інфекцією.







